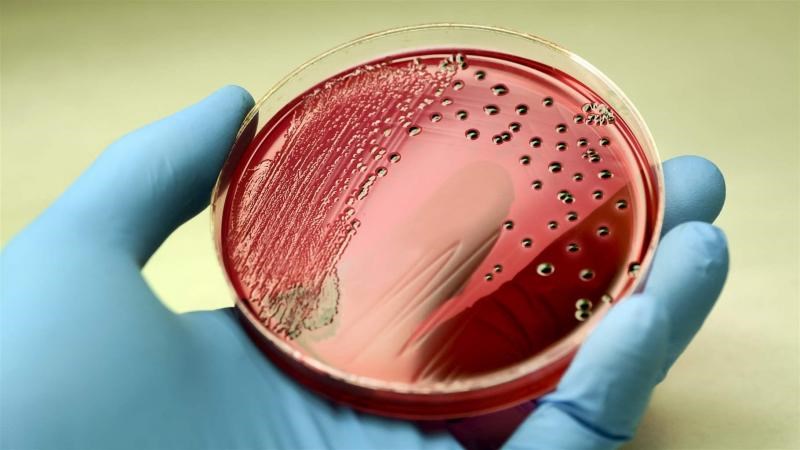

Bệnh nhiễm trùng máu là gì?
Nhiễm trùng máu (nhiễm khuẩn huyết) là phản ứng quá mức của hệ miễn dịch khi cơ thể bị nhiễm trùng. Sự xâm nhập của vi khuẩn kích thích hệ miễn dịch tiết ra các chất chống lại chúng nhưng nếu phản ứng này mất kiểm soát sẽ gây tổn thương các cơ quan bình thường, dẫn đến trình trạng viêm lan rộng khắp cơ thể.
Ngoài ra, các phản ứng dây chuyền của nhiễm trùng máu có thể hình thành cục máu đông trong mạch máu, làm giảm lưu lượng máu đến các bộ phận.
Nhiễm trùng máu có 3 giai đoạn:
- Nhiễm trùng máu: Vi khuẩn xâm nhập vào máu và gây viêm.
- Nhiễm trùng máu nặng: Tình trạng nhiễm trùng và viêm nghiêm trọng hơn, ảnh hưởng đến chức năng của các cơ quan.
- Sốc nhiễm trùng: Biến chứng nghiêm trọng gây tụt huyết áp đáng kể, có thể dẫn đến các biến chứng khác như rối loạn chức năng đa cơ quan, suy hô hấp, suy tim, đột quỵ, thậm chí là tử vong.
Vì đây là tình trạng nguy hiểm đến tính mạng nên nhiễm trùng máu cần được chẩn đoán và điều trị càng sớm càng tốt.
1Các bệnh nhiễm trùng đường hệ tiêu hoá – gan mật
Vi khuẩn xâm nhập vào hệ tiêu hoá – gan mật gây ra một số tình trạng bệnh lý trước khi bệnh phát triển nhiễm trùng máu. Điểm chung của các bệnh lý này là nếu không được điều trị, các tác nhân gây bệnh (vi khuẩn, vi rút, ký sinh trùng) sẽ đi qua thành cơ quan vào đường máu, gây viêm lan rộng đến các vùng khác. Một số bệnh đường tiêu hoá có thể gây nhiễm trùng huyết như:
- Viêm ruột thừa;
- Các vấn đề đường ruột;
- Viêm phúc mạc;
- Nhiễm trùng túi mật, nhiễm trùng gan.
Để hạn chế nguy cơ mắc bệnh nhiễm trùng đường tiêu hoá, mọi người nên sử dụng thực phẩm sạch, có nguồn gốc rõ ràng, ăn uống hợp vệ sinh, bổ sung lợi khuẩn và các sản phẩm hỗ trợ tiêu hoá.

Các bệnh nhiễm trùng đường hệ tiêu hoá – gan mật có thể dẫn đến nhiễm trùng huyết
2Viêm ở hệ thống thần kinh trung ương
Viêm màng não và viêm tuỷ có nguyên nhân xuất phát từ sự xâm nhập của vi khuẩn, virus hoặc nấm. Viêm màng não, viêm tuỷ do vi khuẩn nếu không được điều trị kịp thời có thể gây nhiều di chứng nguy hiểm, trong đó có nhiễm trùng máu, thậm chí gây tử vong.
Trẻ sơ sinh là đối tượng dễ bị tổn thương, có nguy cơ cao mắc các vi khuẩn gây viêm màng não, đồng thời cũng dễ gặp phải nhiễm trùng máu do hệ miễn dịch chưa phát triển hoàn thiện.
Đây là bệnh nguy hiểm, có thể gây tử vong trong thời gian ngắn, do đó cần tiêm vaccine đầy đủ cho trẻ em và người lớn để phòng ngừa bệnh và hạn chế các biến chứng nghiêm trọng.

Viêm màng não, viêm tuỷ do vi khuẩn có thể gây ra nhiễm trùng máu
3Viêm phổi
Viêm phổi là tình trạng viêm và có dịch trong phổi do nhiễm vi khuẩn, vi rút, hoặc nấm gây ra. Viêm phổi là nguyên nhân phổ biến nhất dẫn đến nhiễm trùng máu, đặc biệt là viêm phổi mắc tại cộng đồng (Community – acquired pneumonia – CAP). Viêm phổi cộng đồng là bệnh truyền nhiễm cấp tính, lây lan sang người do tiếp xúc với giọt bắn của người bệnh khi nói chuyện, ho, hắt hơi.
Viêm phổi có thể gây viêm cục bộ và toàn thân, dẫn đến rối loạn phản ứng miễn dịch trong cơ thể, dẫn đến nhiễm trùng máu, thậm chí là nhiễm trùng máu nặng và sốc nhiễm trùng.
Vì viêm phổi là bệnh truyền nhiễm, có thể gây biến chứng nhiễm trùng máu nên mọi người cần chú ý có biện pháp bảo vệ sức khoẻ như tiêm vaccine, vệ sinh vùng tai mũi họng, giữ ấm cơ thể vào mùa lạnh, dùng các sản phẩm bổ phế, hô hấp,…

Viêm phổi là một nguyên nhân phổ biến của nhiễm trùng máu
4Các bệnh nhiễm trùng da
Vi khuẩn có thể xâm nhập vào máu thông qua các vết thương hở trên da hoặc tại các vị trí đặt ống thông y tế. Do đó, nhiễm trùng máu có khả năng xảy ra hậu phẫu thuật, tuy nhiên tình trạng này rất hiếm gặp.
Ngoài ra, bệnh viêm mô tế bào cũng là nguyên nhân khởi phát của nhiễm trùng máu. Đây là một bệnh khá phổ biến, có biểu hiện là nhiễm khuẩn cấp tính dưới da. Như các bệnh khác, biến chứng của bệnh này do số lượng vi khuẩn di chuyển vào máu và gây viêm tại các cơ quan của cơ thể.

Các bệnh nhiễm trùng da có thể gây biến chứng nhiễm trùng máu
5Nhiễm trùng đường tiết niệu
Nhiễm trùng đường tiết niệu là một loại nhiễm trùng rất phổ biến trong hệ thống tiết niệu, bao gồm niệu đạo, niệu quản, bàng quang và thận.
Nhiễm trùng đường tiết niệu có thể dẫn đến viêm thận, viêm đài bể thận, phát tán vi khuẩn vào máu, gây nhiễm khuẩn huyết.
Bệnh này không khó điều trị, có thể dùng kháng sinh, vì thế nguy cơ tử vong từ nhiễm trùng máu do nhiễm trùng đường tiết niệu là thấp nhất so với các nguyên nhân khác.
Xem thêm: Nguyên nhân viêm đường tiết niệu có thể bạn chưa biết

Nhiễm trùng đường tiết niệu có khả năng phát tán vi khuẩn vào máu
6Khi nào gặp bác sĩ?
Các dấu hiệu cần gặp bác sĩ
Nhiễm trùng máu thường không có triệu chứng rõ ràng, nhưng bạn có thể dựa vào một số biểu hiện sau đây:
- Tăng nhịp tim hoặc giảm nhịp đập
- Sốt, run rẩy, cảm thấy lạnh
- Nhầm lẫn, mất phương hướng
- Hụt hơi
- Đau, khó chịu
- Đổ mồ hôi nhiều
Nhiễm trùng máu là một tình trạng cấp cứu nguy hiểm đến tính mạng. Nếu bạn hoặc người thân mắc các bệnh viêm hoặc nhiễm trùng nhưng lâu ngày không cải thiện hoặc trở nặng hơn, hãy đến bệnh viện để kịp thời chẩn đoán và chữa trị.

Nhiễm khuẩn huyết là tình trạng khẩn cấp y tế, không nên chủ quan
Chẩn đoán
- Xét nghiệm cấy máu: kiểm tra sự hiện diện của vi khuẩn trong máu.
- Xét nghiệm máu: để kiểm tra chức năng gan, thận, các vấn đề về đông máu và chất điện giải.
- Xét nghiệm mức độ oxy trong máu
- Xét nghiệm nước tiểu
- Xét nghiệm hình ảnh: XQuang hoặc chụp CT.

Xét nghiệm cấy máu giúp nhận biết vi khuẩn trong máu
Các địa điểm khám uy tín
Nếu bạn hoặc người thân muốn được chẩn đoán và tư vấn chuyên môn về nhiễm khuẩn huyết, bạn có thể đến Trung tâm Xét nghiệm máu của các bệnh viện trong khu vực của bạn. Một số bệnh viện uy tín bạn có thể tham khảo:
- TP. Hồ Chí Minh: Bệnh viện Chợ Rẫy, Bệnh viện Y Dược TP.HCM, Bệnh viện Bệnh Nhiệt đới,…
- Hà Nội: Bệnh viện Bạch Mai, Bệnh viện Đại học Y Hà Nội, Bệnh viện Đa khoa Đống Đa,…
Nhiễm trùng máu là một trong những nguyên nhân gây tử vong hàng đầu, những bệnh nhân có tiền sử nhiễm trùng các hệ cơ quan trong cơ thể nên đặc biệt quan tâm. Nếu thấy bài viết này hữu ích, hãy chia sẻ cho bạn bè, người thân cùng đọc nhé!
Nguồn: Healthline, MedlinePlus